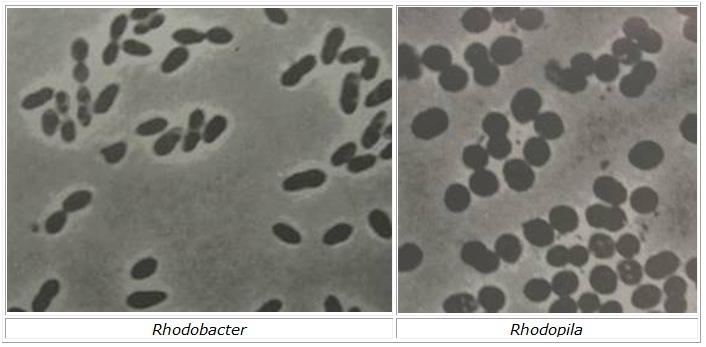

Vi khuẩn không lưu huỳnh màu tía (Nonsulfure purple bacteria)
Vi khuẩn không lưu huỳnh màu tía là nhóm vi khuẩn quang dị dưỡng hữu cơ (photoorganoheterotrophs) thường kỵ khí bắt buộc, một số loài là quang tự dưỡng vô cơ không bắt buộc (trong tối là hoá dị dưỡng hữu cơ- chemoorganoheterotrophs). Tế bào chứa chlorophyl a hoặc b, hệ thống quang hợp chứa các màng hình cầu hay hình phiến (lamellar) gắn với màng sinh chất. Để dùng làm nguồn cho điện tử (electron donors) trong quang hợp thường sử dụng chất hữu cơ, đôi khi sử dụng hợp chất lưu huỳnh dạng khử hoặc H2. Có khả năng di động với tiên mao mọc ở cực, hoặc không di động, một số loài có túi khí (gas vesicles), tỷ lệ G+C là 61-72%.
- Chi Blastochloris
- Chi Phaeospirillum
- Chi Rhodobacter
- Chi Rhodobium
- Chi Rhodocista
- Chi Rhodocyclus
- Chi Rhooferax
- Chi Rhodomicrobium
- Chi Rhodoplanes
- Chi Rhodopila
- Chi Rhodopseudomonas
- Chi Rhodospira
- Chi Rhodospirillum
- Chi Rhodothalassium
- Chi Rhodovibrio
- Chi Rhodovulum
- Chi Rosespira
- Chi Rubiviva